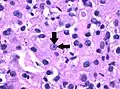
Grade 3: Arrows point at a clearly visible nucleolus.

Clear-cell renal-cell carcinoma (CCRCC) is a type of renal-cell carcinoma.
Genetics
Cytogenetics
- Alterations of chromosome 3p segments occurs in 70–90% of CCRCCs
- Inactivation of von Hippel–Lindau disease (VHL) gene by gene mutation and promoter hypermethylation
- Gain of chromosome 5q
- Loss of chromosomes 8p, 9p, and 14q
Molecular genetics
Several frequently mutated genes were discovered in CCRCC: VHL, KDM6A/UTX, SETD2, KDM5C/JARID1C and MLL2. PBRM1 is also commonly mutated in CCRCC.
Histogenesis
CCRCC is derived from the proximal convoluted tubule.
Microscopy
Generally, the cells have a clear cytoplasm, are surrounded by a distinct cell membrane and contain round and uniform nuclei.
Microscopically, CCRCCs are graded by the ISUP/WHO as follows:[1][2]
- Grade 1: Inconspicuous and basophilic nucleoli at magnification of 400 times
- Grade 2: Clearly visible and eosinophilic nucleoli at magnification of 400 times
- Grade 3: Clearly visible nucleoli at magnification of 100 times
- Grade 4: Extreme pleomorphism or rhabdoid and/or sarcomatoid morphology
Epidemiology
- CCRCC most commonly affects male patients in their sixties and seventies.
- Majority of cases arise sporadically.
- Only 2–4% of the cases presenting as part of an inherited cancer syndrome, such as von Hippel–Lindau disease.
Images
 Clear-cell renal-cell carcinoma. Macroscopy
Clear-cell renal-cell carcinoma. Macroscopy Clear-cell renal-cell carcinoma. HE, × 100
Clear-cell renal-cell carcinoma. HE, × 100_Nephrectomy.jpg.webp) Clear-cell renal-cell carcinoma. Fuhrman grade = 1. HE, × 400
Clear-cell renal-cell carcinoma. Fuhrman grade = 1. HE, × 400 Grade 3: Arrows point at a clearly visible nucleolus.
Grade 3: Arrows point at a clearly visible nucleolus.
References
- ↑ YiFen Zhang. "What is the ISUP/WHO grading system for renal cell carcinoma (RCC)?". Medscape. Updated: Jul 02, 2019
- ↑ Moch, H. (2016). "WHO-ISUP-Graduierungssystem für Nierenkarzinome". Der Pathologe. 37 (4): 355–360. doi:10.1007/s00292-016-0171-y. ISSN 0172-8113.
This article is issued from Wikipedia. The text is licensed under Creative Commons - Attribution - Sharealike. Additional terms may apply for the media files.